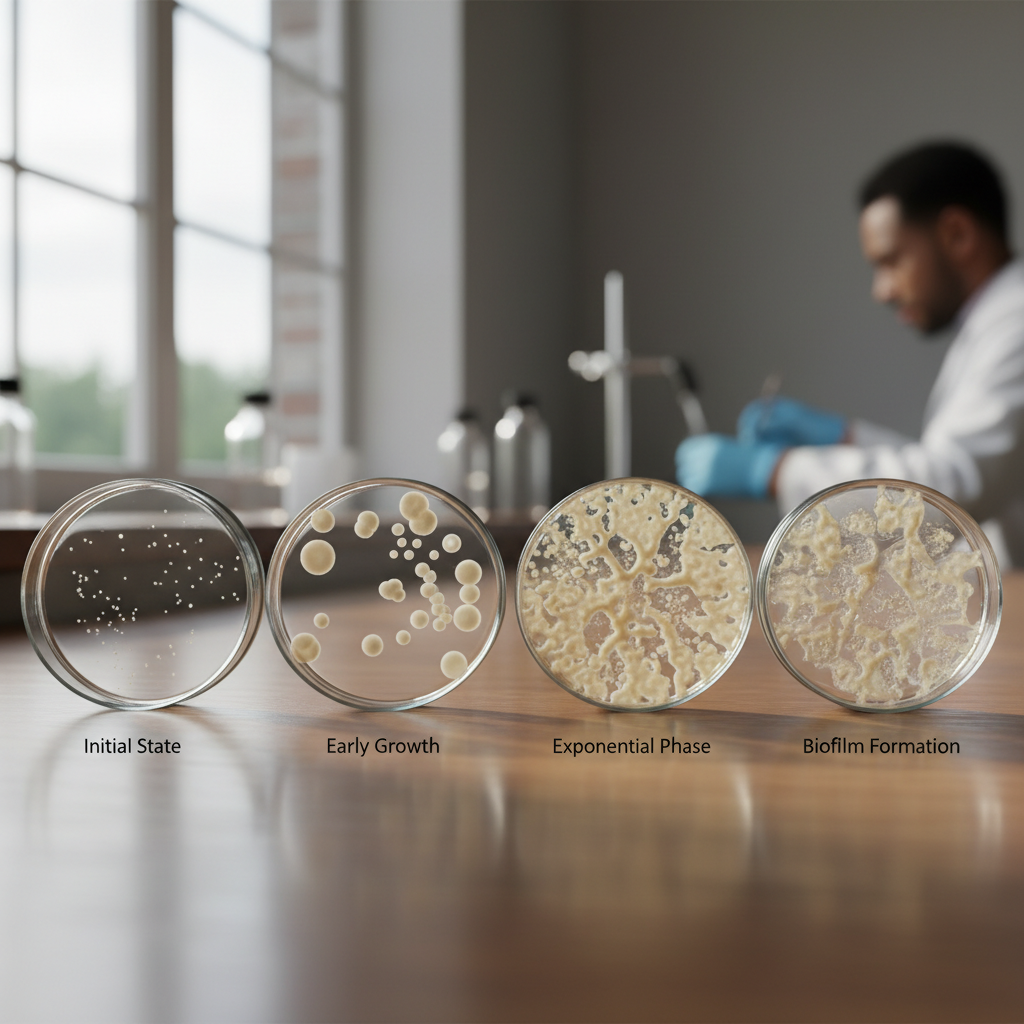

14 Common Antibiotic Questions — Answered by Healthcare Professionals
Antibiotics represent one of the most revolutionary discoveries in medical history, fundamentally transforming healthcare and saving countless lives since Alexander Fleming's accidental discovery of penicillin in 1928. These powerful medications work by either killing bacteria or inhibiting their growth, making them essential tools in treating bacterial infections ranging from minor skin conditions to life-threatening sepsis. However, despite their widespread use and critical importance, antibiotics remain surrounded by confusion, misconceptions, and concerning patterns of misuse that contribute to the growing global crisis of antibiotic resistance. Healthcare professionals consistently encounter the same questions from patients who seek clarity about proper antibiotic use, effectiveness, side effects, and the complex relationship between these medications and our body's natural defenses. Understanding these fundamental aspects of antibiotic therapy is not merely academic—it's a crucial component of responsible healthcare that affects individual treatment outcomes and global public health. This comprehensive exploration addresses the fourteen most frequently asked questions about antibiotics, drawing from evidence-based medical research and expert clinical experience to provide clear, actionable answers that empower patients to make informed decisions about their healthcare while contributing to the broader effort to preserve antibiotic effectiveness for future generations.
1. What Exactly Are Antibiotics and How Do They Work?

Antibiotics are specialized pharmaceutical compounds designed to combat bacterial infections through two primary mechanisms: bactericidal action, which directly kills bacteria, and bacteriostatic action, which inhibits bacterial growth and reproduction. These medications target specific bacterial structures or processes that are either absent in human cells or significantly different from human cellular mechanisms, allowing them to selectively attack pathogens while minimizing damage to the host. The most common targets include bacterial cell walls (targeted by penicillins and cephalosporins), protein synthesis machinery (targeted by aminoglycosides and macrolides), DNA replication processes (targeted by quinolones), and metabolic pathways (targeted by sulfonamides). Each antibiotic class has evolved to exploit specific vulnerabilities in bacterial physiology, which explains why different antibiotics are effective against different types of bacteria. For instance, penicillin disrupts the synthesis of peptidoglycan, a crucial component of bacterial cell walls, causing the bacteria to burst due to osmotic pressure. Understanding these mechanisms helps explain why antibiotics are completely ineffective against viral infections, as viruses lack the cellular structures and independent metabolic processes that antibiotics target. This fundamental difference between bacterial and viral pathogens is crucial for patients to understand, as it underlies the importance of accurate diagnosis before antibiotic prescription and explains why antibiotics cannot treat common viral illnesses like colds, flu, or most cases of bronchitis.
2. Why Don't Antibiotics Work Against Viral Infections?

The fundamental reason antibiotics are ineffective against viral infections lies in the vastly different biological structures and life cycles of viruses compared to bacteria. While bacteria are complete, independent cellular organisms with their own cell walls, ribosomes, DNA replication machinery, and metabolic pathways that antibiotics can target, viruses are essentially genetic material (DNA or RNA) wrapped in a protein coat that lacks these structures entirely. Viruses cannot reproduce independently and instead hijack the host cell's own machinery to replicate, making them essentially intracellular parasites that are protected by the very human cells they infect. This means that any medication designed to kill viruses would need to target processes occurring within human cells, creating a significant risk of damaging healthy tissue. Additionally, the rapid mutation rate of many viruses allows them to quickly develop resistance to antiviral medications, making treatment challenging even when specific antiviral drugs are available. Common viral infections such as the common cold, influenza, most cases of bronchitis, and many gastrointestinal illnesses will resolve on their own as the immune system recognizes and eliminates the viral invaders. Taking antibiotics for these conditions not only provides no benefit but can actually cause harm by disrupting the body's natural bacterial flora, potentially leading to secondary infections, digestive issues, and contributing to the development of antibiotic-resistant bacteria. Healthcare professionals emphasize that viral infections typically require supportive care—rest, hydration, symptom management—rather than antimicrobial intervention, and that the body's immune system is remarkably effective at clearing viral infections when given adequate time and support.
3. How Long Should I Take Antibiotics and Why Is Completing the Course Important?

The duration of antibiotic treatment is carefully calculated based on extensive research into bacterial elimination kinetics, the specific infection being treated, the antibiotic's pharmacological properties, and the time required to prevent the development of resistance. Most antibiotic courses range from three to fourteen days, with the exact duration determined by factors including the infection site, severity, causative organism, and patient-specific considerations such as immune status and kidney function. The critical importance of completing the entire prescribed course cannot be overstated, as stopping antibiotics prematurely—even when symptoms have resolved—can lead to treatment failure and the emergence of antibiotic-resistant bacteria. When antibiotics are discontinued early, the most susceptible bacteria are eliminated first, but hardier, potentially resistant bacteria may survive and multiply, leading to a relapse of infection that is more difficult to treat. This phenomenon, known as selective pressure, is one of the primary drivers of antibiotic resistance development. Healthcare professionals explain that symptoms often improve before all bacteria are eliminated because the reduction in bacterial load decreases inflammation and toxin production, but microscopic numbers of bacteria may still remain viable and capable of causing reinfection. The prescribed duration ensures that antibiotic levels remain therapeutic long enough to eliminate even the most persistent bacteria and prevent the selection of resistant strains. Patients should understand that each dose builds upon the previous one to maintain consistent drug levels in the body, and that missing doses or stopping early can compromise treatment effectiveness and contribute to the global crisis of antibiotic resistance that threatens the future effectiveness of these life-saving medications.
4. What Are the Most Common Side Effects of Antibiotics?

Antibiotic side effects range from mild and temporary to severe and potentially life-threatening, with the specific risk profile varying significantly among different antibiotic classes and individual patient factors. The most frequently reported side effects involve the gastrointestinal system, including nausea, vomiting, diarrhea, and abdominal cramping, which occur because antibiotics not only target pathogenic bacteria but also disrupt the beneficial bacterial flora that normally inhabit the digestive tract. This disruption can lead to an overgrowth of harmful organisms such as Clostridium difficile, potentially causing severe colitis that requires immediate medical attention. Other common side effects include allergic reactions ranging from mild skin rashes to severe anaphylaxis, particularly with penicillin-based antibiotics, which affect approximately 8-10% of the population. Photosensitivity reactions are notable with certain antibiotics like tetracyclines and fluoroquinolones, making patients more susceptible to sunburn and requiring careful sun protection during treatment. Some antibiotics can cause specific organ-related side effects: aminoglycosides may affect hearing and kidney function, requiring monitoring during treatment; fluoroquinolones have been associated with tendon rupture and peripheral neuropathy; and certain antibiotics can interact with other medications, affecting blood clotting or altering the effectiveness of birth control pills. Healthcare professionals emphasize the importance of reporting any unusual symptoms during antibiotic treatment, as early recognition and management of side effects can prevent serious complications. Patients should also be aware that some side effects, such as mild digestive upset, are common and manageable, while others, such as severe allergic reactions, difficulty breathing, or persistent diarrhea, require immediate medical attention and may necessitate discontinuation of the antibiotic and alternative treatment approaches.
5. Can I Drink Alcohol While Taking Antibiotics?

The interaction between alcohol and antibiotics is a complex topic that varies significantly depending on the specific antibiotic involved, with some combinations being merely inadvisable while others can be genuinely dangerous. The most serious interaction occurs with metronidazole and tinidazole, which can cause a severe disulfiram-like reaction when combined with alcohol, resulting in symptoms including severe nausea, vomiting, flushing, rapid heartbeat, and potentially dangerous drops in blood pressure. This reaction occurs because these antibiotics inhibit aldehyde dehydrogenase, the enzyme responsible for metabolizing alcohol, leading to toxic accumulation of acetaldehyde in the body. Other antibiotics, such as certain cephalosporins and sulfamethoxazole-trimethoprim, may cause similar but less severe reactions in some individuals. Beyond these specific interactions, alcohol consumption during antibiotic treatment can impair the immune system's ability to fight infection, potentially prolonging illness and reducing treatment effectiveness. Alcohol also shares some metabolic pathways with certain antibiotics, potentially altering drug levels in the body and affecting therapeutic outcomes. Additionally, both alcohol and some antibiotics can cause similar side effects such as nausea, dizziness, and gastrointestinal upset, and combining them may intensify these symptoms and make it difficult to distinguish between normal side effects and signs of complications. Healthcare professionals generally recommend avoiding alcohol during antibiotic treatment not only to prevent potential interactions but also to support optimal immune function and recovery. Patients should be particularly cautious with liquid medications that may contain alcohol, and should always inform their healthcare providers about their alcohol consumption patterns to ensure safe prescribing practices and appropriate monitoring during treatment.
6. Why Do Some Antibiotics Need to Be Taken with Food While Others Don't?

The timing of antibiotic administration in relation to meals is determined by complex pharmacokinetic factors that affect how the medication is absorbed, distributed, and utilized by the body, with food interactions significantly influencing therapeutic effectiveness and side effect profiles. Some antibiotics, such as amoxicillin-clavulanate and erythromycin, are better absorbed when taken with food, which also helps reduce gastrointestinal irritation and nausea that can occur when these medications contact the stomach lining directly. Food can enhance absorption by stimulating gastric acid production, which helps dissolve certain antibiotic formulations, or by slowing gastric emptying, allowing more time for drug absorption in the small intestine. Conversely, other antibiotics like tetracycline and ciprofloxacin should be taken on an empty stomach because food, particularly dairy products and foods high in calcium, magnesium, or iron, can bind to these medications and form insoluble complexes that prevent absorption. This chelation effect can reduce antibiotic levels in the bloodstream by up to 50%, potentially leading to treatment failure and increased risk of resistance development. The fat content of meals can also affect absorption of certain antibiotics; for example, high-fat meals can increase the absorption of some medications while decreasing others. Healthcare professionals emphasize that these timing requirements are not arbitrary suggestions but critical factors that can determine treatment success or failure. Patients should carefully follow specific instructions provided with their prescriptions, understanding that "with food" typically means during or within 30 minutes of eating, while "on an empty stomach" means at least one hour before or two hours after meals. When in doubt, patients should consult their pharmacist or healthcare provider rather than guessing, as improper timing can significantly compromise treatment effectiveness and potentially contribute to the development of antibiotic resistance.
7. What Should I Do If I Miss a Dose of Antibiotics?

Missing antibiotic doses can significantly impact treatment effectiveness by creating gaps in therapeutic drug levels that allow bacteria to recover and potentially develop resistance, making it crucial for patients to understand proper strategies for managing missed doses. The general rule is to take the missed dose as soon as possible, unless it's almost time for the next scheduled dose, in which case patients should skip the missed dose and continue with the regular schedule rather than doubling up. However, this approach varies depending on the specific antibiotic's half-life, dosing frequency, and the time elapsed since the missed dose. For antibiotics taken multiple times daily, such as amoxicillin every eight hours, a dose missed by a few hours can usually be taken late without significantly disrupting the treatment schedule. However, for once-daily antibiotics or extended-release formulations, the timing becomes more critical, and patients may need to adjust subsequent doses to maintain appropriate intervals. Healthcare professionals emphasize that maintaining consistent antibiotic levels in the body is essential for preventing bacterial regrowth and resistance development, as fluctuating drug concentrations create selective pressure that favors the survival of more resistant bacterial strains. Patients should never double doses to "catch up," as this can lead to toxic drug levels and increased side effects without providing additional therapeutic benefit. Instead, they should contact their healthcare provider or pharmacist for specific guidance, particularly if multiple doses have been missed or if they're unsure about timing. To prevent missed doses, patients can use pill organizers, smartphone reminders, or link antibiotic administration to daily routines like meals or bedtime. Understanding that consistent dosing is as important as completing the full course helps patients appreciate why adherence to the prescribed schedule is crucial for both individual treatment success and broader public health efforts to combat antibiotic resistance.
8. Can Antibiotics Affect Birth Control and Other Medications?

Antibiotic interactions with other medications represent a significant clinical concern that can affect treatment efficacy, increase side effect risks, and lead to unexpected therapeutic failures, making it essential for patients to disclose all medications, supplements, and herbal products to their healthcare providers. The most clinically relevant interaction involves certain antibiotics and oral contraceptives, where antibiotics like rifampin can significantly reduce contraceptive effectiveness by inducing liver enzymes that metabolize estrogen and progestin more rapidly, potentially leading to unintended pregnancy. While most common antibiotics like amoxicillin and azithromycin have minimal impact on birth control effectiveness, healthcare professionals often recommend backup contraceptive methods during antibiotic treatment as a precautionary measure, particularly given individual variations in metabolism and the serious consequences of contraceptive failure. Antibiotics can also interact with anticoagulant medications like warfarin, potentially increasing bleeding risk by altering gut bacteria that produce vitamin K or by affecting liver metabolism of the anticoagulant. Some antibiotics, particularly fluoroquinolones, can interact with antacids, iron supplements, and calcium-containing products, forming complexes that prevent antibiotic absorption and reduce therapeutic effectiveness. Additionally, certain antibiotics can affect blood sugar control in diabetic patients, either by altering gut bacteria that influence glucose metabolism or through direct effects on insulin sensitivity. The timing of medication administration becomes crucial when interactions are possible; for example, separating antibiotic doses from antacids by several hours can prevent absorption problems. Healthcare professionals emphasize the importance of maintaining an updated medication list that includes prescription drugs, over-the-counter medications, vitamins, and herbal supplements, as even seemingly benign products can interact with antibiotics in unexpected ways. Patients should never stop or start medications without consulting their healthcare provider during antibiotic treatment, and should report any unusual symptoms that might indicate drug interactions.
9. How Do Bacteria Develop Resistance to Antibiotics?
Antibiotic resistance develops through several sophisticated biological mechanisms that bacteria have evolved over millions of years, representing one of the most pressing challenges in modern medicine and highlighting the importance of responsible antibiotic use. The primary mechanism involves genetic mutations that alter bacterial proteins targeted by antibiotics, such as changes in cell wall synthesis enzymes that make beta-lactam antibiotics ineffective, or modifications in ribosomal binding sites that prevent protein synthesis inhibitors from working. Bacteria can also acquire resistance genes from other bacteria through horizontal gene transfer mechanisms including conjugation (direct transfer through cell-to-cell contact), transformation (uptake of free DNA from the environment), and transduction (transfer via bacteriophages), allowing resistance traits to spread rapidly through bacterial populations even across different species. Another significant mechanism involves the production of enzymes that directly inactivate antibiotics, such as beta-lactamases that break down penicillin and related antibiotics, or the development of efflux pumps that actively remove antibiotics from bacterial cells before they can exert their effects. The overuse and misuse of antibiotics creates selective pressure that favors resistant bacteria, as sensitive bacteria are eliminated while resistant strains survive and multiply, eventually becoming the dominant population. This process is accelerated when antibiotics are used inappropriately for viral infections, when courses are not completed, when antibiotics are used in subtherapeutic doses, or when broad-spectrum antibiotics are used unnecessarily. Healthcare professionals emphasize that resistance development is a natural evolutionary response that can occur even with appropriate antibiotic use, but inappropriate use dramatically accelerates the process and can lead to the emergence of multidrug-resistant organisms that are extremely difficult to treat. Understanding these mechanisms helps explain why antibiotic stewardship—using the right antibiotic, at the right dose, for the right duration, for the right indication—is crucial for preserving the effectiveness of these life-saving medications for future generations.
10. Are There Natural Alternatives to Antibiotics?

While numerous natural substances possess antimicrobial properties and have been used in traditional medicine for centuries, it's crucial to understand that these alternatives cannot replace prescription antibiotics for treating serious bacterial infections, though they may play supportive roles in maintaining health and preventing minor infections. Honey, particularly Manuka honey, has demonstrated significant antibacterial activity due to its low pH, high osmolarity, and production of hydrogen peroxide, with clinical studies showing effectiveness against certain wound infections and as an adjunct to conventional treatment. Garlic contains allicin, a compound with broad-spectrum antimicrobial properties that has shown activity against various bacteria, fungi, and viruses in laboratory studies, though its effectiveness in treating established infections in humans remains limited compared to prescription antibiotics. Tea tree oil, oregano oil, and other essential oils have demonstrated antimicrobial activity in vitro, but their use requires caution due to potential toxicity, skin irritation, and variable quality among commercial preparations. Probiotics represent a different approach, working not by directly killing pathogens but by supporting the body's natural bacterial flora, which can help prevent infections and reduce the risk of antibiotic-associated complications like C. difficile colitis. However, healthcare professionals emphasize that while these natural substances may have preventive benefits or supportive roles, they should never be used as primary treatment for serious bacterial infections such as pneumonia, sepsis, or meningitis, where delayed or inadequate treatment can be life-threatening. The appeal of natural alternatives often stems from concerns about antibi
